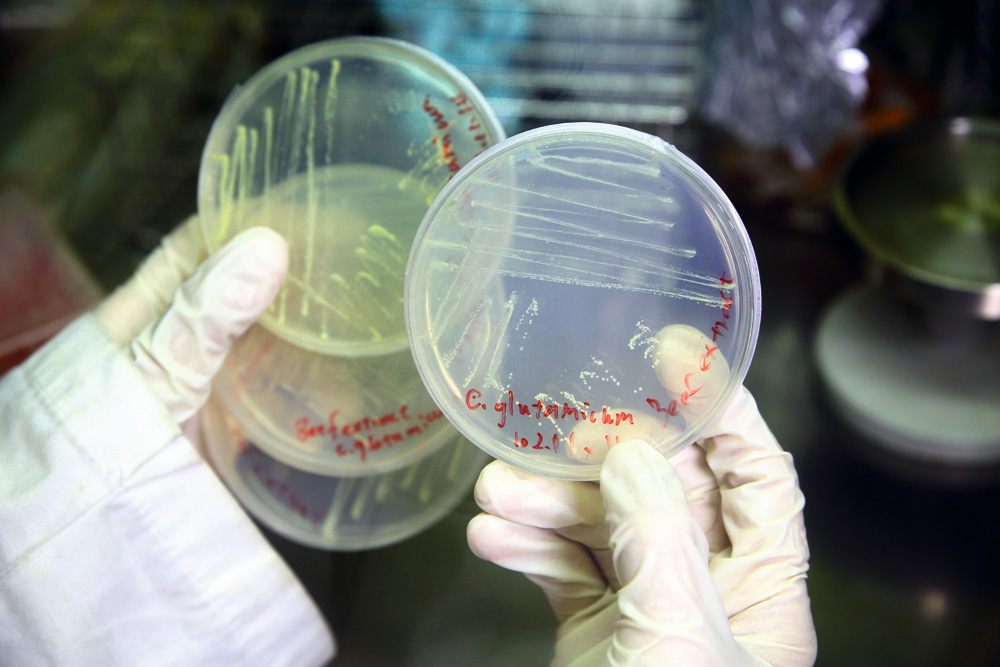

Bee. coli Saves Bees, NYMU Clinches World Championship
Chang Chiung-fang / photos Chin Hung-hao / tr. by Chris Nelson
February 2014
In October 2013, the NYMU-Taipei team, organized by National Yang Ming University, won the gold medal for the Asian region at the International Genetically Engineered Machine (iGEM) Competition in Hong Kong, advancing to the world championship. Then in November they went to the US to compete in the finals, where they defeated over 20 teams, including Yale and MIT, to clinch the award for Best Environment Project.
Working on the topic of saving bees, the NYMU-Taipei team achieved astonishing results, evoking public curiosity about what the iGEM competition is about and how NYMU-Taipei was able to distinguish itself.
iGEM is the world’s biggest contest in synthetic biology, having expanded from its start in 2004 as a small contest at MIT. It is chiefly about creative design in genetic engineering: designing and building biological systems out of special DNA components that can be introduced into living organisms, where they perform their functions.
A total of five teams from Taiwan registered to compete in 2013, coming from National Yang Ming University (NYMU), National Taiwan University, National Chiao Tung University, and Tzu Chi University. The NYMU-Taipei team stood out among 204 participating teams from around the globe. It was a remarkable achievement.

The three-pronged attack of Bee. coli to block fungal infections in honeybees: controlling fungus germination, killing fungi infecting the bee’s gut, and killing bees with out-of-control infections to prevent infection of other bees in the hive.
Headed by professors Chang Chuan-hsiung and Jane Chang of the Center for Systems and Synthetic Biology at National Yang Ming University and Li Wan-chun of NYMU’s Department of Dentistry, the NYMU-Taipei team is in its seventh year of competing in iGEM since 2007, and has accumulated plenty of experience in the process.
“This is a student competition. Faculty can only help from the sidelines,” stresses iGEM team advisor Chang Chuan-hsiung. Each year, the research topic is proposed and discussed by the students themselves, with little input from faculty members in the decision.
Every year, the NYMU-Taipei team openly recruits new members. There are no restrictions as to major: students can join as long as they’re willing to devote a year of extracurricular time and effort to preparing for the competition.
“Training new members is a difficult process,” says Chang. The members in 2013 started from a pool of 40 or 50, but only 21 diehards remained in the end.
Team captain Lawrence Chen, a third-year medical student, has dedicated two years in a row to the team. He says he has gained valuable interdisciplinary learning experience from brainstorming proposals, attending basic courses to boost his skills, conducting group experiments, and producing reports.
The results of the projects are presented at the iGEM competition in the form of a poster and an oral presentation. Second-year NYMU medical student Liao Rou-chien was one of three members in charge of the oral presentation and Q&A session. “The university students themselves direct, plan and research, and present the findings to the world. Such an exchange opportunity is very hard to come by,” says Liao with confidence.

The NYMU-Taipei team recruits new researchers every year. The prize-winning experience of the team veterans is both a goal and a form of pressure for new members.
Chang Chuan-hsiung explains that synthetic biology is a new interdisciplinary science linking engineering and biology. If the life sciences involve the “reverse engineering” of deconstructing cells, then synthetic biology is the “forward engineering” of building and packaging genetic components.
“The iGEM competition’s chief focus is creativity,” says Chang, citing the 2013 project as an example. Students started out with unrestrained brainstorming, then selected one theme from over 200 topics, and finally attempted to address it with synthetic biology techniques.
Xiao Youyu is the student who proposed the topic of saving bees. Her grandfather raises honeybees, and in bygone years they always had copious harvests of royal jelly, but in recent years there’s been a significant decrease in production. This is what sparked her idea of saving bees.
The creative ideas flowing from other universities were also remarkable. Chang Chuan-hsiung gives an example: in 2013, a team engineered the bacterium Escherichia coli (E. coli) to give off different odors at different stages. During its mass reproductive stage, it would discharge a banana odor, and in the stable stage it would emit a minty scent. So when food gives off a banana odor, we know it has gone bad.

Under the direction of synthetic biology professor Chang Chuan-hsiung, medical student Liao Rou-chien has learned a lot as part of the NYMU-Taipei team. Pictured on the facing page are Petri dishes containing E. coli to be used to save bees.
The iGEM competition is judged on the feasibility, practical value, creativity and presented results of the students’ designs. In 2013, the NYMU-Taipei team won five major awards all having to with the urgency of the issue of vanishing honeybees and the practicalities of designing and developing Bee. coli.
Back in 2006, Western countries started seeing massive die-offs in honeybee colonies. Worker bees failed to return to their hives, and their bodies were nowhere to be found. And inside the hives there remained just a small number of house bees, larvae and eggs, as well as the queen, none of which were able to gather food. This led to the disintegration and death of the colony. The phenomenon was dubbed Colony Collapse Disorder.
NYMU-Taipei’s report noted that 40–50% of honeybees in the US died in 2012, leading to losses of US$150 million.
Honeybees are nature’s most important pollinator for many plants; without bees gathering nectar from flowers, humans would lose a third of their food sources. Apples, cauliflowers, cucumbers, pumpkins, alfalfa, cotton, almonds and other plants that rely on bee pollination would be affected.
The causes of the disappearance of honeybees are complex. Some scholars attribute it to global climate change and a resulting loss of habitat, and others are convinced it’s due to contamination by herbicides or pesticides. There are also the problems of viral infections and fungal parasitism.
Chang Chuan-hsiung says that while most Western scholars are targeting their research at pesticides, the NYMU-Taipei team used modified E. coli to tackle a fungal infection that causes starvation in bees, thereby eliminating one of the multiple factors threatening honeybees.
Fungi such as molds are often present in the environment in the form of spores, which grow when nutrients are plentiful and growth conditions are favorable. In a honeybee infected with the fungus Nosema ceranae, the spores produce polar filaments, which penetrate the epithelial cells in the bee’s gut. Then, as the fungus reproduces, it absorbs nutrients from the gut, and the bee dies from malnutrition.
Bee. coli’s threefold mechanismIn their research, the NYMU-Taipei team modified E. coli to attack the fungal parasite using a method similar to “cocktail therapy.”
This modified form of E. coli, christened “Bee. coli” by the research team, is coated with a special chemical substance. This is made into capsules which are mixed into the sugar water that beekeepers use as bee feed. The mixture is then dried into crystalline pellets, which the bees ingest. This substance attacks the fungal parasites.
The design of Bee. coli incorporates a three-pronged attack: it prevents the fungus from embedding itself inside the bee’s gut, it kills fungi already within the bee, and it kills bees whose infections have gone out of control.
Chang Chuan-hsiung explains that the polar filaments of the spores are coated with a sugar known as mannose. When the protein FimH comes into contact with the mannose, it binds to it, thus blocking spore germination and so rendering the fungus unable to enter the bee’s epithelial cells and multiply.
Once the cells in a bee’s gut are infected by the fungus, an immune reaction in the gut cells triggers the release of reactive oxygen species (ROS). These prompt Bee. coli to produce antibiotic proteins called defensins that kill the fungus.
In the event that there are uncontrollable quantities of fungus within the bee that are unable to be eliminated, then Bee. coli activates a bee-killing mechanism, producing two enzymes in the bee’s gut that catalyze the synthesis of alcohol, destroying the bee’s brain. The bee dies within two hours, preventing it from returning to the hive and infecting healthy bees, which would result in mass death.
According to Chang, they chose E. coli because it’s quite easy to insert genes into E. coli. Furthermore, E. coli is unable to survive if released into the wild, so there’s no worry about harming the environment.
Even so, NYMU-Taipei still incorporated an E. coli killing mechanism into their design. Once excreted by the bee, the bacteria will die instantly, preventing the modified E. coli from escaping into the wild and killing other fungi.
Chang says that the next step is to replace the E. coli with Lactobacillus, which is already found within the digestive tracts of honeybees. “Lactobacillus already lives inside bees; it’s a beneficial microbe and can protect their immunity,” he says.
Savior of the beesThe Bee. coli process developed by the NYMU-Taipei team conforms to the principles of synthetic biology, but it also has practical potential.
After the conclusion of the contest, some team members stayed on to continue with their research, hoping to apply their findings to help prevent Colony Collapse Disorder. Chang says that they’re now applying to patent the entire control mechanism.
When news of the Bee. coli project winning the world championship reached Taiwan’s beekeeping industry, beekeepers called in, hoping that the team would visit their farms to assess the infection status. Some beekeepers even transported moldy hives up north to Chang, hoping he could address the tricky problem of fungal infection.
Whether Bee. coli, developed by the NYMU-Taipei team, will become the savior of the bees is a dramatic sequel waiting to be seen.
@List.jpg?w=522&h=410&mode=crop&format=webp&quality=80)
@List.jpg?w=522&h=410&mode=crop&format=webp&quality=80)
@List.jpg?w=522&h=410&mode=crop&format=webp&quality=80)



